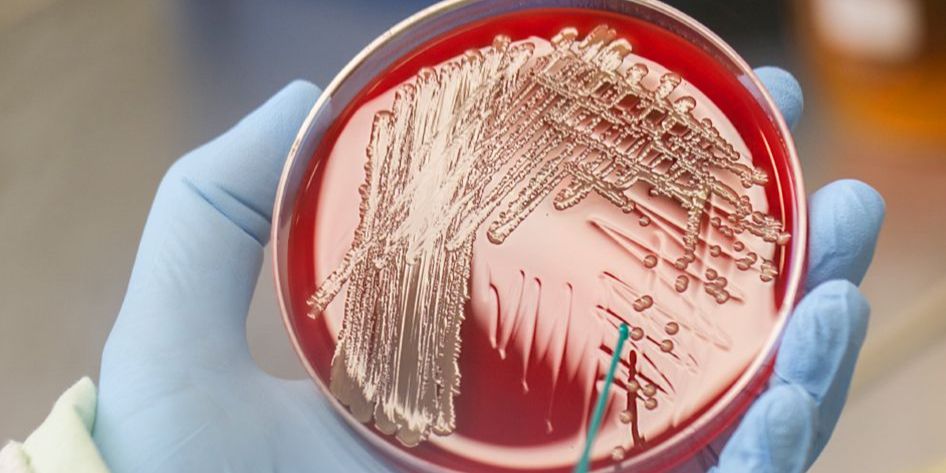
Superkeim vom indischen Subkontinent analysiert

Superkeim vom indischen Subkontinent analysiert
Ein internationales Forscherteam hat erstmals die Evolution und Verbreitungswege eines speziellen Stammes von Methicillin-resistenten Staphylococcus aureus MRSA im Detail analysiert. Der sogenannte „Bengal Bay“-Klon vereint eine besondere Virulenz und das Potential zur weltweiten Ausbreitung mit der Multiresistenz von Krankenhauskeimen. Für die aufwändige Analyse arbeiteten 38 Wissenschaftler aus 15 Ländern mehr als acht Jahre lang zusammen. InfectoGnostics-Forscher des Leibniz-Instituts für Photonische Technologien und von Abbott in Jena waren maßgeblich an der Analyse der Gensequenzen beteiligt. cd/Foto: InfectoGnostics/Fotostudio Ebenbild





















 Überwiegend bewölkt
Überwiegend bewölkt 






